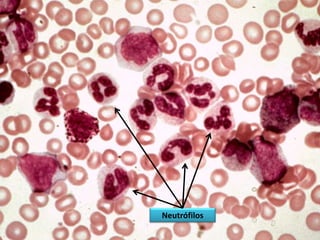
Neutrófilo   Mielocito




                   Neutrófilos
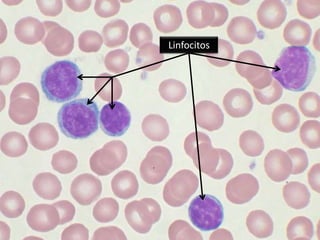
Linfocitos
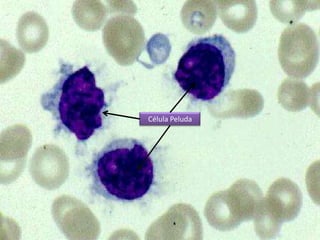
Célula Peluda
   9

Este documento describe las leucemias crónicas más comunes en México, incluyendo la granulocítica, linfocítica y de células peludas. Estas se caracterizan por un curso indolente y larga evolución sin células muy indiferenciadas, distinguiéndolas de la leucemia aguda. El tratamiento busca controlar los síntomas y mejorar la calidad de vida, aunque rara vez puede lograr la curación excepto mediante trasplante de médula ósea.